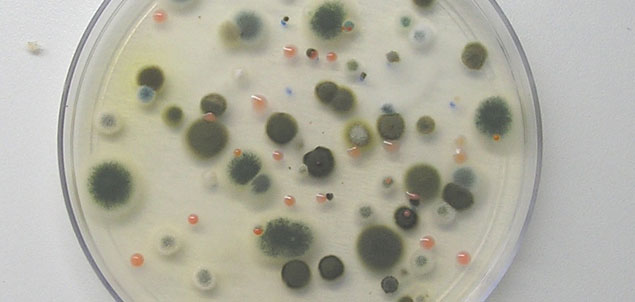
baterias

Durante séculos, os guardiões da sabedoria antiga e curandeiros de várias tradições tinham uma profunda compreensão do corpo energético. As tradições de cura da China, Índia, Japão e Tibete, assim como de outros países, todas falavam de canais energéticos, meridianos ou nadis ao longo do qual a energia vital fluia.
A vida era considerada um fenómeno bio-eléctrico e de energia vibracional, e assim a saúde girava em torno do equilíbrio energético através dos vários processos. A vida existia por causa da força da vida e da energia que atravessa e anima o corpo, garantindo que ele se pode mover, respirar e digerir alimentos, pensar e até mesmo sentir.
Canais Energéticos
Esta força vital ou chi, é composta por dois tipos de forças, yin e yang, e os fluxos ao longo de uma sofisticada rede de vias energéticas, que formam um circuito no corpo. À mais de 2000 anos atrás as culturas antigas sabiam da existência desses canais energéticos. Eles eram chamados de “sen” na Tailândia, “nadis” na Índia, “meridianos”, “canais” ou “vasos” na China e no Japão, e “canais” no Tibete. Na Índia, onde muitas artes de cura orientais se desenvolveram, afirmava-se que existiam cerca de 72 000 nadis ou canais energéticos. As doenças acreditavam-se ser resultado de um bloqueio no fluxo energético nesses canais. Uma série de tradições de cura, incluindo a acupuntura, acupuntura por pressão, massagem e ioga, são alicerçadas no princípio da existência de canais energéticos ou vias, conhecidos como meridianos ou nadis, fluindo ao redor do corpo numa extensa rede.
Embora ainda possa parecer um conto de fadas para alguns considerar o corpo energético, enquanto nós temos carne e osso, na fonte nós somos uns campos energéticos, embutidos noutro campo de energia. Os nossos corpos são naturalmente eletromagnéticos e a ciência mediu estas frequências com máquinas avançadas, como ECG e ressonâncias magnéticas, durante muitos anos. Numerosos estudos demonstram que estas vias energéticas e pontos conduzem a electricidade mesmo quando as agulhas não estão a ser utilizadas. E provou-se que a técnica de massagem Shiatsu gera os mesmos efeitos energéticos. Da mesma forma demonstrou-se que o Qigong, o Tai Chi e as posturas do yoga, aumentam a condutância eléctrica nos pontos de acupuntura, mas até agora a ciência convencional nunca tinha acreditado na existência dos meridianos.
A Pesquisa Científica
Recentemente cientistas da Universidade Nacional de Seul confirmaram a existência de meridianos, aos quais se referem como o “sistema primo-vascular.” Eles dizem que este sistema é uma parte crucial do sistema cardiovascular.
Anteriormente, o cientista norte-coreano Kim Bong-Han propôs a descoberta dos meridianos no início de 1960. O Dr. Kim Bong-Han mostrou à mais de 50 anos que as novas estruturas tubulares existiam dentro e fora dos vasos sanguíneos e vasos linfáticos, bem como sobre a superfície dos órgãos internos e sob a derme. Ele acreditava que eles eram os meridianos tradicionais. Os meridianos foram chamados de dutos ou canais Bonghan, após a sua pesquisa, mas agora a existência deste sistema em vários órgãos é corroborada por novas pesquisas.
Os investigadores coreanos, atualmente, acreditam agora que o sistema primo-vascular é de fato o componente físico do Sistema de Meridianos da Acupuntura. E também tem sido sugerido que este sistema está envolvido na canalização do fluxo energético e da informação transmitida pelos biofótons (ondas electromagnéticas de luz).
Os cientistas coreanos injetaram um corante especial que coloriu os meridianos. Ao injetar o corante nos pontos de acupuntura, eles foram capazes de ver as finas linhas. Estas não apareceram em pontos que não eram de acupuntura, onde não haviam meridianos. Os pesquisadores descobriram que os meridianos não estão confinados à pele mas são, na realidade, um verdadeiro sistema de canais através do qual o líquido flui, e que este líquido se agrega para formar as células-estaminais.
Anteriormente, os cientistas usaram uma combinação de técnicas de imagem e tomografia computadorizada para observar pontos concentrados de estruturas microvasculares, que correspondem claramente ao mapa dos pontos de acupuntura criado pelos praticantes de medicina energética chineses na antiguidade. Num estudo publicado no Journal of Electron Spectroscopy and Related Phenomena, os pesquisadores usaram tomografia computadorizada por contraste com a radiação incidente em ambos os pontos, os de não-acupuntura e os pontos de acupuntura. As tomografias revelaram distinções claras entre os pontos de não-acupuntura e os pontos de acupuntura das estruturas anatômicas.

O sistema de meridianos
Existem 12 meridianos principais emparelhados e dois meio-meridianos individuais, seis yang e seis yin. Os meridianos yang percorrem o corpo de cima para baixo, e os meridianos yin fluem de baixo para cima. Cada meridiano também está relacionado com um elemento. Cada meridiano é mais ativo num determinado momento do dia ou da noite, e cada meridiano é influenciado por um elemento ou temporada.
A natureza dos meridianos, na sua estrutura elementar e como canais para a força vital, mostram a complexidade e profunda ligação do nosso corpo ao nível celular, com o universo. Estamos intimamente ligados pelos elementos, estrutura energética e fluxo de energia, para toda a vida, ao nível celular e físico. Sobre o nosso planeta também é dito que tem vias energéticas, as chamadas linhas de Ley, semelhantes aos meridianos.
Como estão os meridianos relacionados com a saúde?
O nosso corpo precisa de equilíbrio. Um fluxo ou energia equilibrado, não demasiado ou muito pouco, é propício a uma boa saúde. É análogo à forma como vivemos as nossas vidas. O equilíbrio é fundamental. Comida e água suficientes e um estilo de vida saudável e equilibrado. Como o Buda disse: “o caminho do meio” ou da moderação em todas as coisas.
Podemos ver essa harmonia e equilíbrio na vida, como o equilíbrio entre as energias yin e yang – ou de forma mais simplista, o masculino e o feminino – as duas energias opostas e catalisadoras do universo.
A nossa saúde é vibrante se houver uma harmonia e equilíbrio entre essas duas forças no corpo. Se o equilíbrio for perturbado, o fluxo de uma destas forças torna-se maior do que o outro e, em seguida, a doença surge. Estas forças ou energias fluem através de canais muito definidos no corpo e estes são as vias energéticas de cura do corpo.
Na medicina tradicional indiana o conceito de meridiano é ainda mais amplo. Existem nadis dentro do corpo físico e esses nadis compõem o sistema nervoso, circulatório, digestivo, respiratório, linfático, etc. Quaisquer bloqueios nestes nadis podem resultar em patologias de saúde física. Os nadis também podem ser encontrados no corpo subtil, onde eles transportam pensamentos, sentimentos e impulsos nervosos. Quando esses nadis estão bloqueados, perdemos a nossa capacidade de sentir, conectarmo-nos profundamente com os outros, com o ambiente e conosco próprios.
Quando o fluxo de energia está bloqueado, ocorre uma quebra de energia e surge a doença. Práticas como o ioga e o trabalho de meditação sobre esses canais de energia sutil, apoiam o fluxo energético através do corpo. De acordo com alguns antigos textos indianos existem 350.000 nadis ou canais energéticos no corpo. Na medicina tradicional indiana e na ciência espiritual as energias do corpo físico, do corpo sutil e do corpo causal diz-se fluir através dos nadis. Neste contexto, os nadis conectam-se em pontos de especial intensidade chamados de nadichakras.
Os três nadis mais importantes são aqueles que funcionam ao longo da espinha: ida, pingala e sushumna. O sushumna é o canal central de energia no corpo humano e que vai da base da coluna até o alto da cabeça e que transporta a energia kundalini, que é a força evolutiva primária. A kundalini é despertada através do yoga e da meditação, e diz-se estar adormecida na base da coluna vertebral. A ativação da kundalini leva a estados de Consciência mais elevados. O objetivo do yoga é o de ampliar o sushumna e unir as vias. Purificar os três nadis leva à boa saúde e bem-estar geral do corpo e da mente, bem como ao crescimento espiritual. Várias técnicas de Pranayama ajudam a manter estes canais de nadi abertos.
Se você é energeticamente sensível e efetuou alguma terapia energética como a acupuntura, poderá ter sentido fluxos de energia ou um fluxo de frio ou calor, por exemplo, a subir pelas pernas ou braços. Este é o sintoma da libertação energética dos meridianos, e do fluxo energético que é libertado quando um bloqueio é removido.
Há muitas modalidades de cura maravilhosas com base no sistema de meridianos, que promovem a saúde. Ao melhorar o fluxo energético através do corpo, o equilíbrio e a saúde são alcançados. A acupuntura é uma modalidade terapêutica utilizada na China desde o final da Idade da Pedra. Foi usada para tratar todas as doenças que afetam as pessoas. A acupuntura não era conhecida no ocidente até a década de 1970, quando a China terminou o período de isolamento e retomou os contatos políticos e culturais com o estrangeiro.
A gama de aplicações para a acupuntura tem crescido lentamente no Ocidente, possivelmente por causa da crença de que não tem nenhuma base científica. Talvez agora, com a prova científica dos meridianos, a acupuntura venha a tornar-se mais generalizada para o tratamento de todas as doenças assim como outras terapias energéticas, promovendo uma saúde mais vibrante e mais bem-estar entre as pessoas.
Fontes:
http://pt.prepareforchange.net/2016/04/21/a-ciencia-finalmente-comprova-a-existencia-dos-meridianos/
http://upliftconnect.com/science-proves-meridians-exist/
https://prisaoplanetaria.com/2016/04/27/a-ciencia-finalmente-comprova-a-existencia-dos-meridianos/
![]()
.
●●● Gostou? Então Curta nossa página no Facebook.
.
![]()
●●● Seja amigo do autor do site no Facebook e esteja sempre antenado em assuntos interessantes.